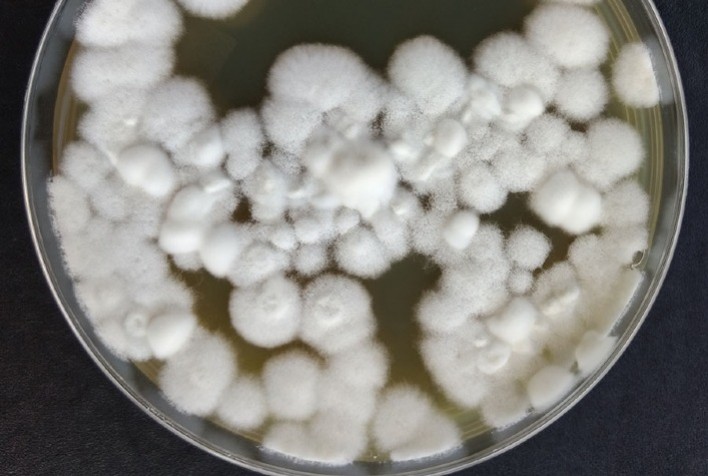
Fungo Modificado Geneticamente Se Torna Mais Eficiente no Controle de Pragas Agrícolas

Fungo Modificado Geneticamente Se Torna Mais Eficiente no Controle de Pragas Agrícolas
Estudo com CRISPR-Cas9 revela que a edição genética pode potencializar bioinseticidas, reduzindo a dependência de pesticidas químicos
Publicado em: 17/03/2025 às 16:00hs
Uma pesquisa conjunta entre cientistas brasileiros e americanos demonstrou que o fungo entomopatogênico Beauveria bassiana pode ser aprimorado no combate a pragas agrícolas por meio de engenharia genética de alta precisão. A utilização da tecnologia CRISPR-Cas9, aplicada para modificar o gene Bbsmr1, mostrou que o fungo pode se tornar mais eficiente na eliminação de insetos, abrindo caminho para bioinseticidas mais potentes e sustentáveis.
De acordo com Gabriel Mascarin, pesquisador da Embrapa Meio Ambiente (SP), a versão inicial do fungo modificado incorpora um gene de resistência (geneticina), o que a classifica como transgênica. Contudo, etapas futuras do estudo visam aplicar a edição genética sem a introdução de DNA de outras espécies. Nesse caso, os fungos modificados seriam considerados convencionais (não-transgênicos), facilitando sua liberação como novos bioinseticidas no Brasil.
Avanços na Pesquisa
No estudo, os cientistas analisaram duas formas do fungo: os blastosporos, células semelhantes a leveduras, e os conídios aéreos, usados em grande parte dos micopesticidas comerciais. Os resultados foram surpreendentes. "Os blastosporos se mostraram 3,3 vezes mais letais e 22% mais rápidos na mortalidade dos insetos do que os conídios", destacou Mascarin. Em apenas cinco dias, os blastosporos alcançaram 97% de mortalidade nas larvas da traça-da-cera (Galleria mellonella), enquanto os conídios atingiram apenas 29,4%.
Além disso, a produção de blastosporos se mostrou mais eficiente, sendo realizada em dois a três dias em cultivo líquido submerso, enquanto os conídios exigem mais de dez dias em cultivo sólido estático. Esses fatores tornam os blastosporos mais atraentes para o desenvolvimento de bioinseticidas e bioacaricidas, possibilitando também uma produção em larga escala mais competitiva.
Mutantes Geneticamente Modificados Mostram Resultados Promissores
A edição do gene Bbsmr1 resultou em mutantes que demonstraram uma letalidade de 50% nos insetos em apenas três dias, mesmo com concentrações reduzidas. O gene modificado também induziu uma germinação mais rápida na cutícula e maior proliferação de blastosporos na hemolinfa dos insetos, superando a cepa selvagem. Além disso, o nocaute do gene Bbsmr1 resultou em uma superprodução de oosporina, substância que compromete o sistema imunológico dos insetos e acelera a mortalidade.
A oosporina, além de contribuir para o controle de pragas, possui propriedades antifúngicas e antibacterianas. Testes mostraram que ela pode atuar como um biofungicida contra patógenos de plantas, como o Fusarium oxysporum, causador de doenças como a murcha-de-fusarium em tomateiros e o mal-do-Panamá em bananeiras.
Precisão da Tecnologia CRISPR-Cas9
A tecnologia CRISPR-Cas9, empregada nesta pesquisa, se destaca pela precisão. Análises genéticas dos mutantes confirmaram que não houve mutações fora do alvo, garantindo a segurança do processo. Fungos aprimorados sem a necessidade de DNA de outras espécies (não-transgênicos) poderão ser liberados com mais rapidez pelos órgãos reguladores, facilitando o desenvolvimento de soluções eficazes para o controle biológico de pragas.
O Impacto do CRISPR-Cas9 na Biotecnologia
O CRISPR-Cas9 é uma tecnologia revolucionária que permite a edição genética precisa e eficiente de microrganismos de interesse agrícola, industrial e médico. Funciona como uma "tesoura molecular", na qual a proteína Cas9, guiada por uma sequência de RNA, corta o DNA em locais específicos, permitindo modificações ou correções genéticas. Essa técnica otimiza a produção de enzimas, biopesticidas e outros metabólitos, além de criar microrganismos mais funcionais e resistentes, proporcionando soluções sustentáveis para diversos setores.
Desafios da Pesquisa e Perspectivas Futuras
Apesar dos avanços, alguns desafios permanecem. Os genes mutantes apresentaram resistência reduzida a estressores químicos e produziram menos conídios em determinadas condições. No entanto, os pesquisadores acreditam ser possível selecionar linhagens sem esses efeitos colaterais, preservando os benefícios da tecnologia, já que a técnica permite gerar diversos mutantes.
A pesquisa demonstra o grande potencial da edição genética para melhorar o uso de fungos entomopatogênicos no controle de pragas. A aplicação dessa tecnologia em outras espécies de fungos de relevância para o controle biológico de pragas pode acelerar o desenvolvimento de soluções eficientes e ambientalmente seguras.
Conclusão
O estudo reforça a importância da biotecnologia como ferramenta na busca por alternativas sustentáveis para o controle de pragas agrícolas. Com o auxílio da tecnologia CRISPR-Cas9 e a superioridade dos blastosporos, o futuro promete um combate mais eficiente às pragas, com maior segurança alimentar e menor dependência de pesticidas químicos.
Equipe de Pesquisa
O estudo foi conduzido por Gabriel Mascarin (Embrapa Meio Ambiente), Somraj Shrestha (Universidade de Auburn, EUA), Márcio Barros Cortes (Embrapa Arroz e Feijão), José Luis Ramirez e Christopher Dunlap (Centro Nacional de Pesquisa em Utilização Agrícola, USDA, EUA) e Jeffrey Coleman (Universidade de Auburn).
Fonte: Portal do Agronegócio
◄ Leia outras notícias